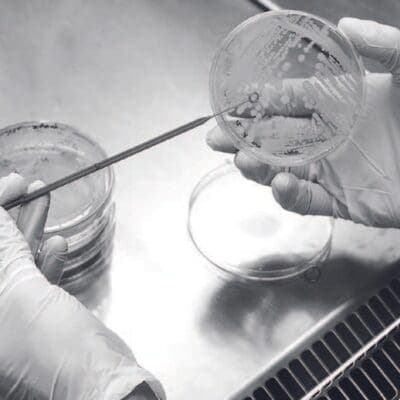
Exploring the Relationship Between the Scalp Microbiome and Dandruff

Articles · May 31, 2024
From Sacred Incense to Commercial Commodity: The Evolution of Perfume
<p>Perfume’s journey from sacred offering to commercial commodity is a fascinating tale spanning centuries and cultures. The story begins in ancient times when the great religions of Christianity, Buddhism, Hinduism, Islam, Shintoism, and Zoroastrianism used perfume in the form of incense to enhance their spiritual practices. They believed that the fragrant smoke of burning incense carried their prayers up to the heavens, making them more pleasing to the gods. Temples played a significant role in this spiritual use of perfume. […]</p>
Euro Cosmetics